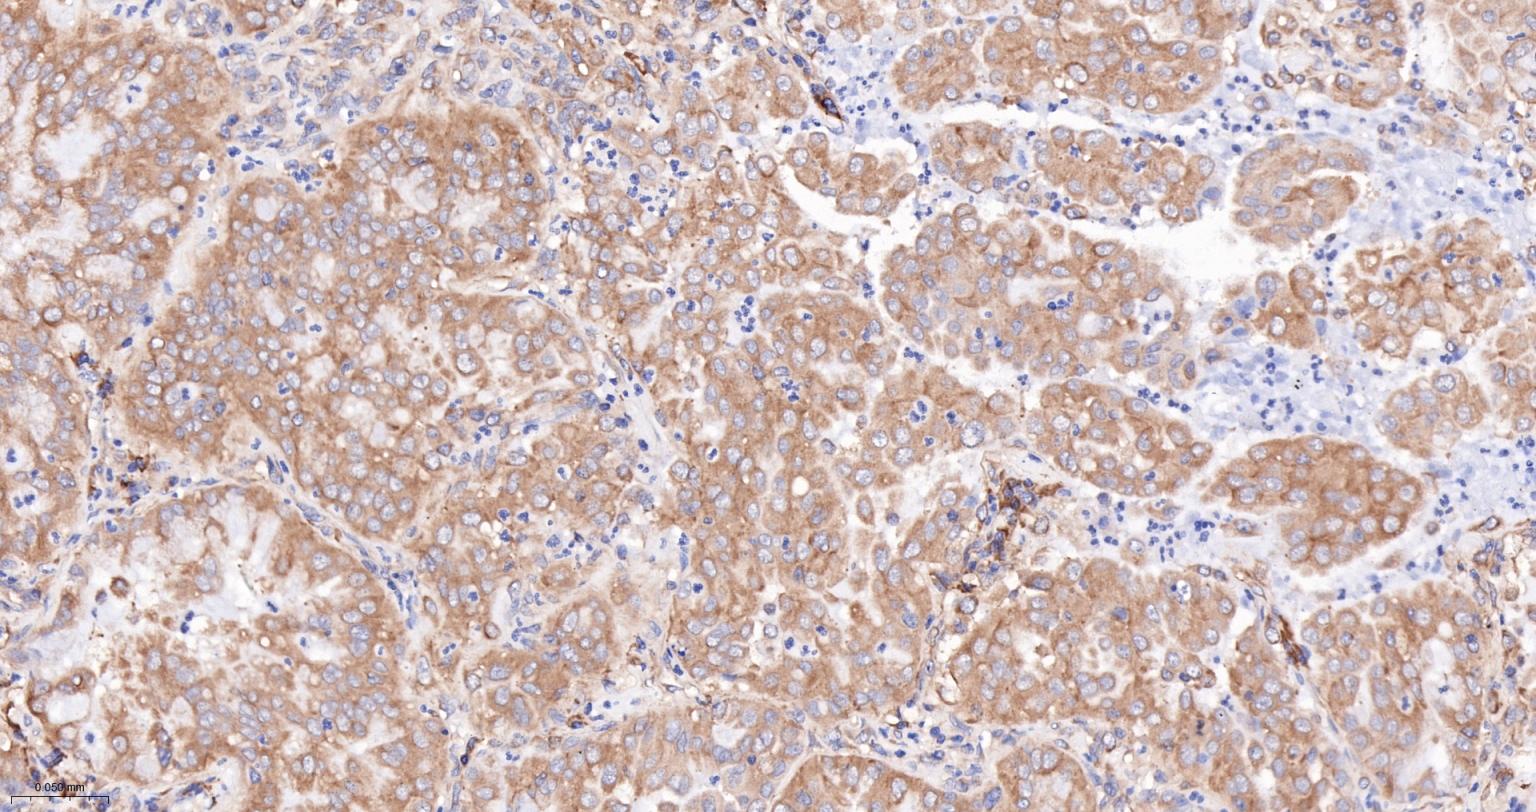
骨形态发生蛋白2重组兔单抗-bsm-61413R
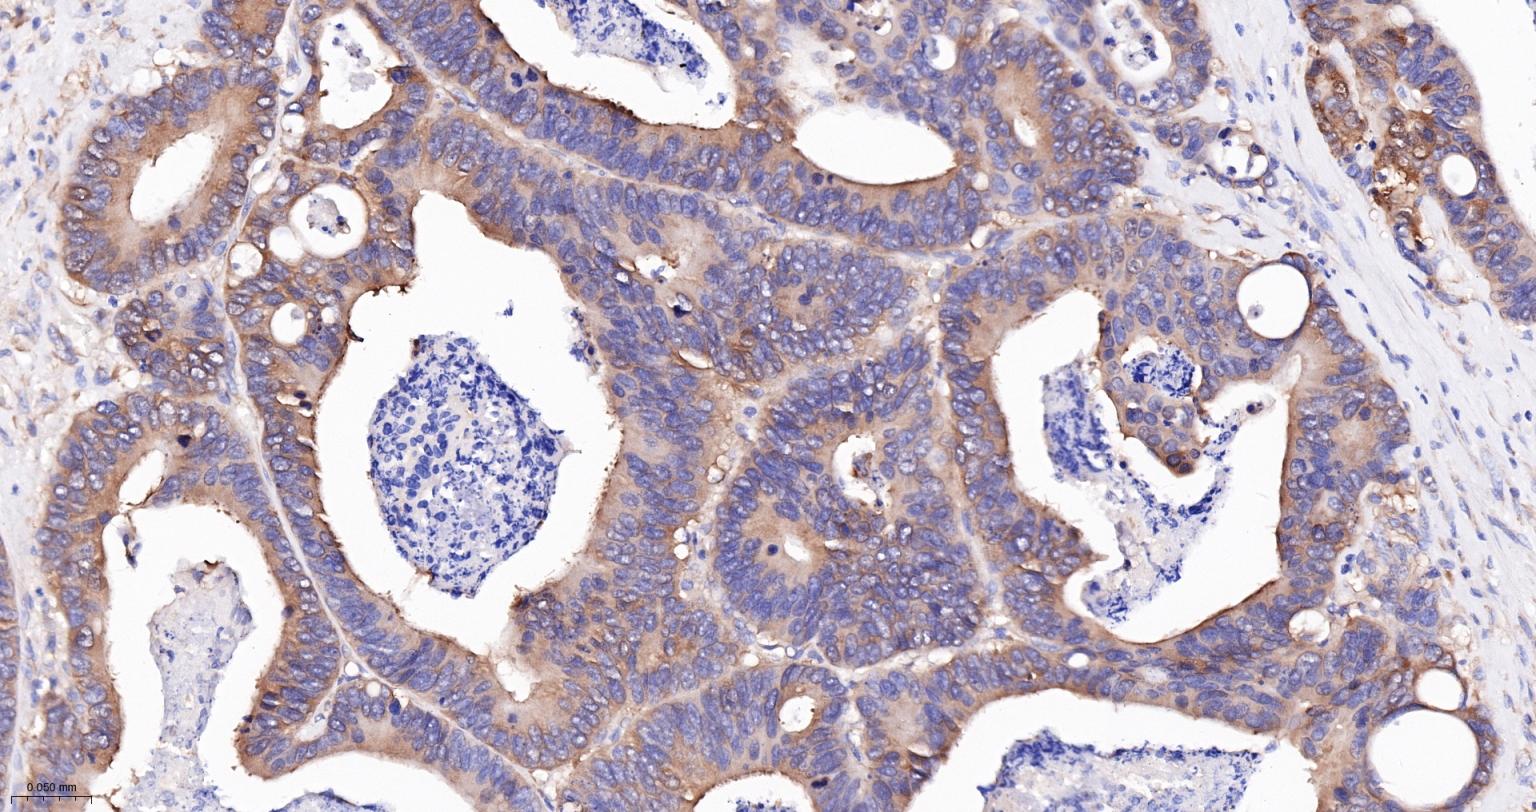
骨形态发生蛋白2重组兔单抗-bsm-61413R
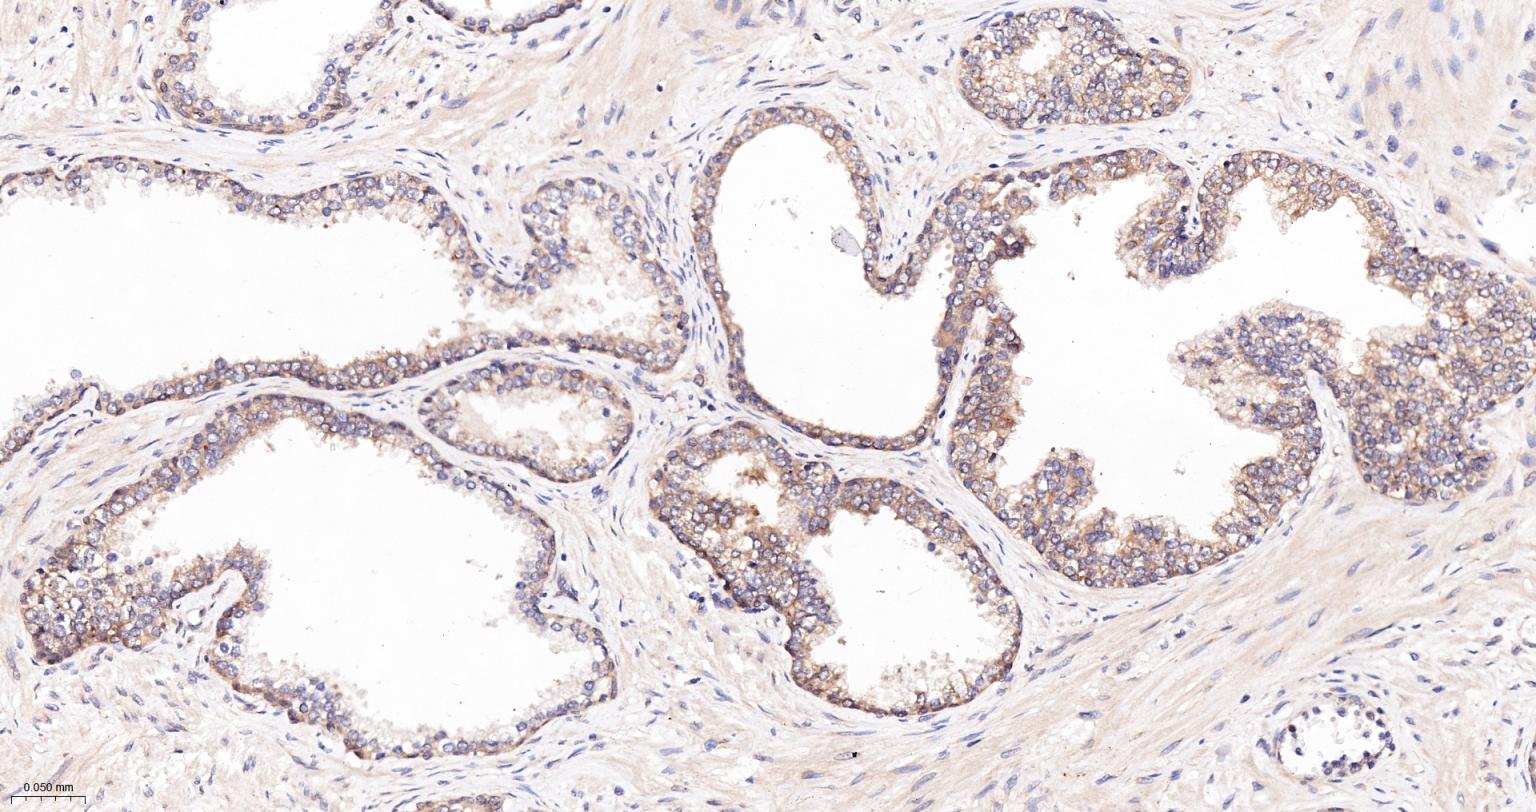
骨形态发生蛋白2重组兔单抗-bsm-61413R

神经干细胞标志物 BMP-2主要对未分化间充质细胞和骨系细胞起到募集和分化作用。在骨形成早期,BMP-2不仅可使未分化间质细胞向骨形成中心募集,并分化为骨系细胞,而且可使成纤维细胞、成肌细胞及骨髓的基细胞逆转分化为骨系细胞。其主要过程是:增加或抑制这些细胞内的某些特异性蛋白的分泌,使成纤维细胞分化为成骨细胞,成肌细胞快速分化为肥大的软骨细胞,并促进基质钙化。 对于成骨细胞,BMP-2则可使之维持其特有细胞表型,并诱导成骨细胞标志物的增高,促进细胞外基质钙化。在骨形成后期,BMP-2还作为一种破骨细胞分化因子与其它支持破骨细胞分化因子直接或间接刺激破骨细胞分化,参与骨的重建。
Growth factor of the TGF-beta superfamily that plays essential roles in many developmental processes, including cardiogenesis, neurogenesis, and osteogenesis. Initiates the canonical BMP signaling cascade by associating with type I receptor BMPR1A and type II receptor BMPR2.

| 应用 | 已检合格种属 | 预测种属 | 推荐稀释比例 |
|---|---|---|---|
| WB | Human | Mouse, Rat | 1:500-1000 |
| IHC-P | Human, Mouse | Rat | 1:200-800 |
| IHC-F | Human, Mouse | Rat | 1:200-800 |
| IF | Human, Mouse | Rat | 1:200-800 |
交叉反应: Human, Mouse (predicted: Rat)
暂无相关产品